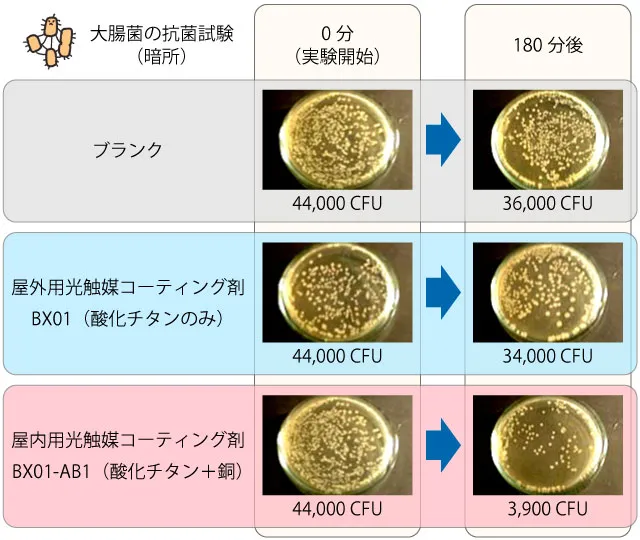
酸化チタンと銅ドープ酸化チタンによる大腸菌の抗菌試験結果（無光）

光触媒は、うまく利用するととても利用価値の高いものです。
光触媒にはいろいろな種類があり、それぞれの光触媒成分を使ったコーティング剤があります。抗菌を目的としたコーティング剤もあります。
そういった、光触媒コーティング剤の中で、防カビコーティングとして利用しても意味の無い光触媒の種類もあります。つまり、抗菌効果の無いものもあります。
光触媒を使って抗菌コーティングをしたい場合は、業者さんに依頼することになりますが、その業者さんがどのような光触媒の種類を使っているのか、依頼する前に確認してください。
抗菌コーティングしても意味の無い光触媒の種類
その種類は、「酸化チタン」です。
業者さんによっては、「酸化チタンは光触媒で、抗菌力や消臭力を発揮します!」とPRしてくると思います。
確かに、酸化チタンは紫外線が当たると、高い効果を発揮します。
ところが、紫外線が当たらなければ、ほとんど効果がありません。
抗菌をしたい場所は、室内のはずです。室内には、紫外線がほとんどありませんから、酸化チタンを使って抗菌コーティングをしても、一般的な照明器具の光では効果がありません。

効果が弱い光触媒の種類
少しばかりは抗菌や消臭ができますが、効果が弱い光触媒の種類は、次の2種類です。
- 窒素ドープ酸化チタン
- 酸化タングステン
これらの光触媒を使った抗菌コーティングは、蛍光灯や白色LEDでも抗菌ができますが、手術室並みの明るい光を当てる必要があります。
昼間の明るいオフィスや、直射日光が射しこんだ場所であれば、抗菌はできますが、夜のリビングやトイレといった薄暗い場所では、抗菌効果は期待できません。
効果の高い光触媒は銅ドープ酸化チタン
室内の抗菌コーティングなら、銅ドープ酸化チタンを使った施工をなさってください。
銅ドープ酸化チタンは、薄暗い部屋でも、窒素ドープ酸化チタンや酸化タングステンといった光触媒よりも、10~20倍以上の効果を発揮します。
しかも、光が当たっているときよりは効果は下がりますが、無光でも抗菌ができます。
次の図は、無光の環境で、大腸菌の抗菌試験をしたものです。一番下のシャーレが、銅ドープ酸化チタンの結果ですが、無光でも大腸菌を抗菌できていることがわかります。
室内を抗菌コーティングするなら、銅ドープ酸化チタンを使った施工をご検討ください。


